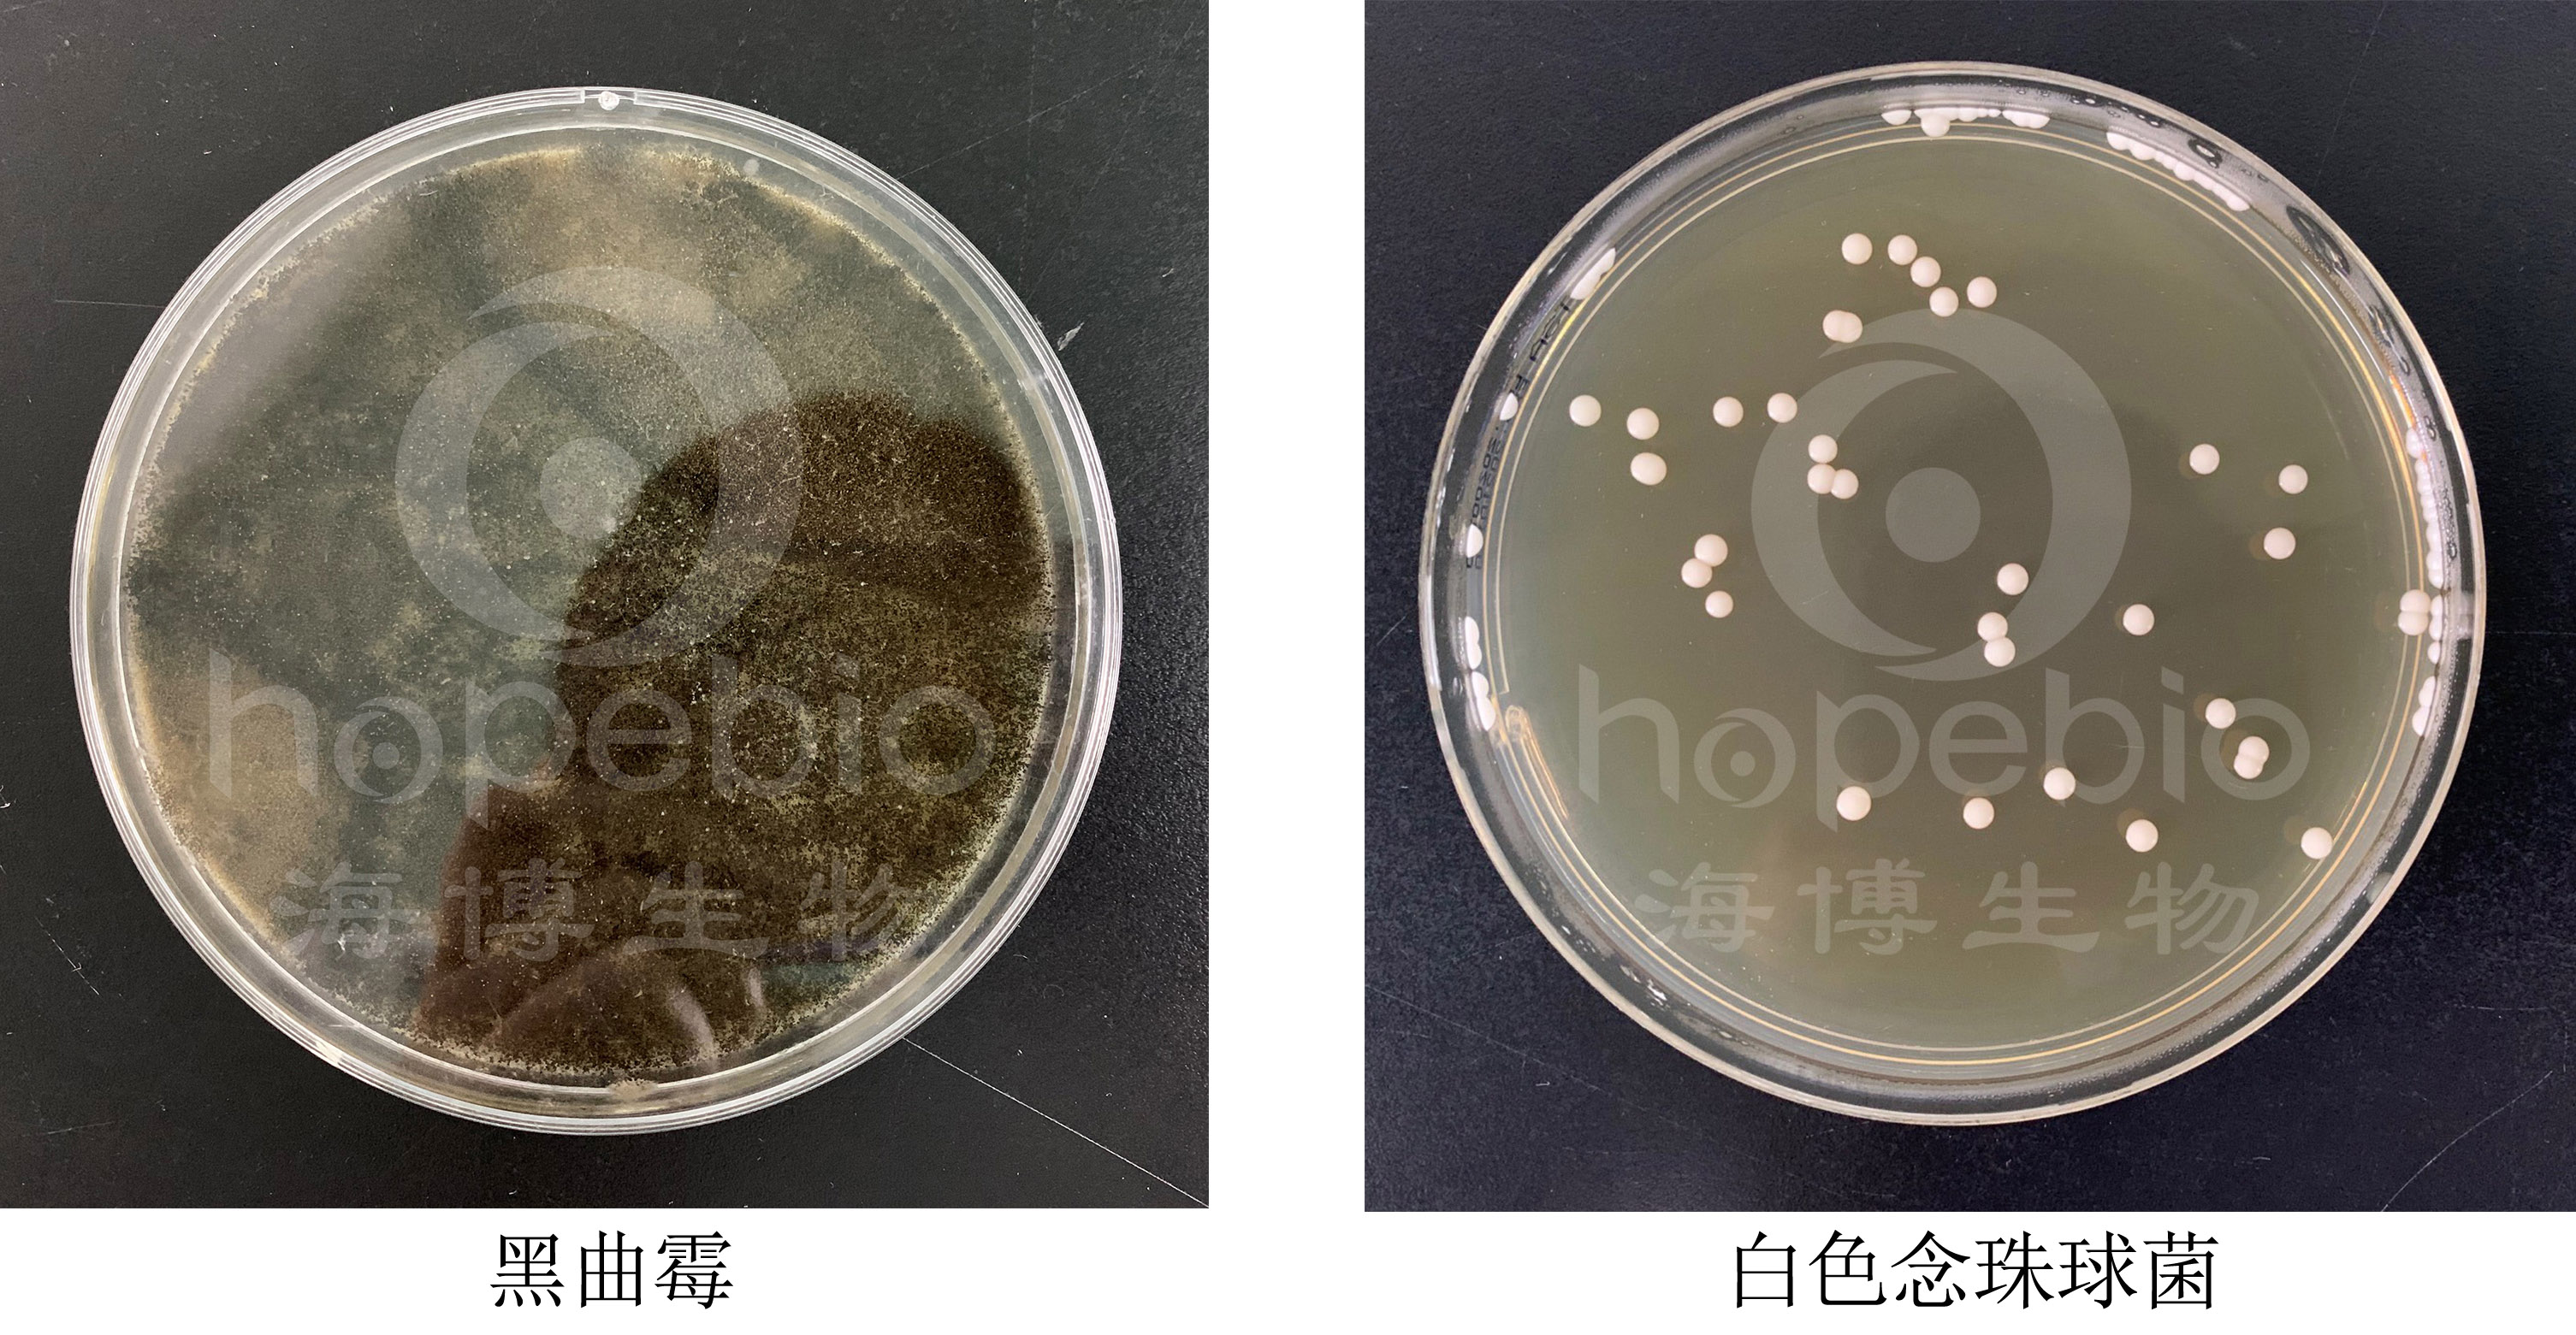

海博微信公众号
海博微信公众号
 海博天猫旗舰店
海博天猫旗舰店


 海博微信公众号
海博微信公众号
 海博天猫旗舰店
海博天猫旗舰店




一、试验原理
本培养基用于真菌的分离。
酵母浸出粉、蛋白胨提供氮源、维生素和矿物质,葡萄糖提供碳源,琼脂是培养基凝固剂。
二、培养基配方(g/L)
|
成分 |
用量 |
|
酵母浸出粉 |
10.0 |
|
葡萄糖 |
40.0 |
|
蛋白胨 |
10.0 |
|
琼脂 |
20.0 |
|
pH5.9-6.1 25℃ |
|
三、试验方法
称取本品 80.0g,加热溶解于1000ml 蒸馏水中,分装,121℃高压灭菌 15 分钟,备用。
四、结果观察与解释
接种以下质控菌株,放置20-25℃需氧培养48-72小时。
注:回收率计算时,用SDA琼脂作对照培养
|
质控菌株 |
菌株编号 |
接种量(CFU) |
方法 |
质控结果 |
其它特征 |
|
黑曲霉 |
ATCC16404 |
10-100 |
定量 |
PR≥0.7 |
有黑色孢子 |
|
白色念珠球菌 |
ATCC10231 |
10-100 |
定量 |
PR≥0.7 |
白色圆形突起菌落 |
SDAY培养基微生物质控结果:
相关产品:
注:本文属海博生物原创,未经允许不得转载。
上一篇:酸性肉汤的实验原理及使用方法
下一篇:半固体培养基的使用方法及质控结果



